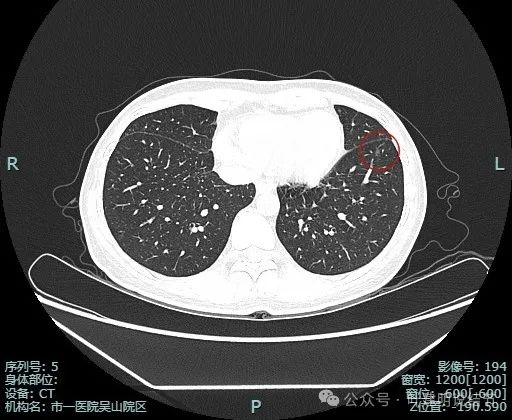
图片

前言:肺结节常见,而临床上不同医生的意见不一致,这是最为令人纠结的事,结友不知道该听谁。这也是我们近些年会一直值得说道与探讨的事,直到有明确的指南或统一的意见可遵循。所以在这纷乱的肺结节诊疗时代,类似的事值得分析、也值得分享,因为有病理结果且结合术前影像细节特征病例分析是能回顾、能探讨、能反思的。今天分享的这位结友查出肺结节已经5年了,来我门诊咨询后,我告诉她可以考虑手术,而且倾向手术了的,结友听从我的建议在杭州市第一人民医院接受了手术,我们来看术后的病理结果,我们的决策是正确的吗?
病史信息:
结友5年前发现左肺结节,定期复查,没有呼吸道症状,也无显著增大。
影像展示与分析:
先看非薄层影像:

左肺淡磨玻璃结节,轮廓与边界较为清楚。

有微小血管走向病灶,而且病灶表面欠平滑。
薄层影像:

病灶离叶间裂较近,几乎贴着,叶间胸膜略有牵拉向病灶侧,但力量小。可见有一细小血管走向病灶。

他处也有小血管进入,整体轮廓与边界清。

边缘显得毛糙。
边缘区也是磨玻璃密度。
靶重建图像:

病灶边缘毛糙,微小血管进入明显。灶内密度略不均。

血管进入与穿行明显,而且在病灶内有发出血管分支,病灶表面不平,有毛刺征。

小血管进入明显,边缘有毛刺征,整体轮廓与边界清。

血管进入,灶内小空泡征,邻近细支气管有扩张,表面有细毛刺。

多处血管征,表面毛糙,轮廓清楚,有不太典型的血管弯征,灶内密度稍不均。

叶间胸膜牵拉较平扫上明显,血管进入也明显,整体轮廓清。

灶内有点状偏高密度成分,内部密度稍显杂乱;叶间胸腊牵拉,整体轮廓清。

多支血管进入,而且灶内的血管显得较病灶外略粗与略模糊,叶间胸膜牵拉是有的,力量不强。
临床考虑:
这是很典型恶性的磨玻璃结节,因为它随访持续存在,磨玻璃密度,灶内密度稍不均;边缘毛糙与细毛刺可见;整体轮廓与边界清;多处血管进入与穿行,灶内血管有异常增粗与壁毛糙;邻近细支气管扩张与灶内小空泡可见;邻近胸膜有轻微牵拉。这些都指向恶性,而由于密度仍以磨玻璃为主,实性成分不显著,所以以微浸润性腺癌或浸润性腺癌贴壁为主型可能性大。手术与否的考虑基于位置、形态、影像特征、随访变化以及结友心理状态和是否多发综合考虑。关键是此灶在肺边缘部位,又有一定风险,我是倾向其单孔局部楔形切了的。当然定要不切,半年复查仍不是说就要转移,但多支血管进入,再随访也不会太久仍预计要进展的。
最后结果:
结友充分考虑后决定接受我的建议来住院手术。我们团队为其进行单孔胸腔镜下左下叶部分切除术。

病灶切面灰白,质较硬,肉眼看就像恶性的。

病理报告示:微浸润性腺癌。
感悟:
有许多结友问诊或门诊时总要我对比之前的有没有变化,是不是大了1毫米、2毫米或有没有指向恶性的空泡征、血管征或胸膜牵拉。其实我常说:若最近的影像已经明显恶性并具一定风险,那么就可以考虑手术的;若最近的影像仍是风险低能随访,那是不必细致对比之前影像的,试想最新的片子仍风险很低,更早的只能更低或没有变化;真正要对比的是目前的影像上看,要不要干预犹豫不决难决断,此时要对比之前的有没有进展,而且要时间跨度最长的对比才最明显。有些结友查过很多次CT,每次的都要我看看有没有变化,真的没有必要,真需要对比的也是看最近与最早的足矣!今天这个病例这次检查的就已经非常能说明问题,所以不必纠结之前的如何,该下手时就下手,当断不断,反受其乱呀。